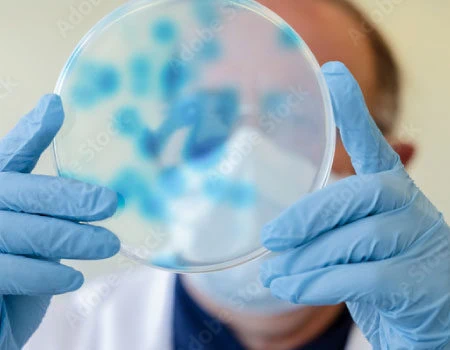

Specialist UK Contract Research Organisation (CRO)
Make the most of your clinical trial budget.
Flexible service options.
Expertise you can trust.
A partner you can scale with.
PHARMExcel is an ISO accredited Contract Research Organisation (CRO) providing Phase I-IV clinical research services to the NHS, Universities, Biopharma and Medical Device industry.
We are not your typical CRO. Through our unwavering reputation in quality, collaboration, and genuine flexibility, we bring a unique personalised approach to clinical trial delivery with a focus on forging a long term, successful partnership.
We have in-depth experience across a broad range of therapeutic areas including Hepatology, Oncology and Haematology, Infectious Diseases and Vaccines, Ophthalmology, Gastroenterology, Probiotics and more. We can deliver across all phases of trials including Device class 1-111.

Our success is based on team work. We have built a solid company culture centred on our core values, respectful interactions and client partnerships. Our staff commitment and drive is seen throughout the organisation which is reflected in our successful trial deliveries.

PHARMExcel is a flexible, full-service CRO delivering integrated clinical trial development, management and monitoring through a coordinated, end-to-end model. Our teams work as an extension of your study leadership, ensuring streamlined delivery, reduced oversight burden and high-quality results across your clinical programme.
0
Founded
0+
Sponsors
0+
Therapy Areas
0+
Years of Staff Experience
One of our core strengths is our commitment and approach. All our clients are treated the same, regardless of size or scope of work. We pride ourselves on fostering strong, collaborative relationships and consider ourselves an extension of your team. Praise from our clients.
"The most collaborative CRO I've worked with. PHARMExcel bothered to know us as a client and undertands our studies inside out, making it an efficient and friendly partnership."
Prof Mark Lowdell, CSO, INKmune Bio Inc
"PHARMExcel's passion for their projects, the flexibility shown by the team, combined with direct access to the CEO, sets PHARMExcel apart from other CROs."
Daniel Green, CEO, Yakrit
"PHARMExcel has been a pleasure to work with, responsive and flexible. "
Professor Saul Faust (OBE), Director, NIHR Southampton Clinical Research Facility
"I have worked with Yvanne Enever and the PHARMExcel team for several years on a complex, multicentre clinical trial. I have found them be efficient, highly professional while being accommodating and very supportive. I have worked with other clinical trial research organisations on similar studies and PHARMExcel have been by far the most effective in achieving targets and the easiest to work with on a day to day basis. "
Dr Kim Orchard, Senior Lecturer and Consultant Haematologist, University Hospital Southampton NHSFT
"Yvanne and her team at PHARMExcel are the best team I’ve worked with in clinical research. They are talented and committed individuals with great expertise in the regulatory landscape as well as delivery of clinical trials. Highly recommended!"
Dr Gautam Mehta, Hepatologist and Principal Investigator, University College London
"It has been a pleasure working with Yvanne and the team. PHARMExcel have been able to work with our clinical research teams to provide bespoke support for a number of trials, including phase 1 trials: the personal approach and attention to detail have given us confidence to ensure patient safety and manage the risks of the Trust acting as Sponsor in particular for the early phase trials."
Karen Underwood & Professor Saul Faust, Sponsor, University Hospital Southampton NHSFT
"PHARMExcel are very interactive and excellent in communicating with clinical teams. They have a thorough understanding of the regulatory requirements for managing GCP compliant clinical trials. I have no hesitation in recommending them as a CRO."
Dr Kim Orchard, Senior Lecturer and Consultant Haematologist University Hospital Southampton NHS FT
"The support from PHARMExcel has been extremely high quality. This includes all aspects trial development, management and monitoring, that was also evidenced by a recent sponsor audit. We look forward to working with PHARMExcel going forwards."
Tom Fletcher, CST-6 Candidate Chief Investigator,Director Global Health Trials Unit, Liverpool School of Tropical Medicine
"PHARMExcel’s passion for their projects, the professionalism shown by the team, combined with direct access to the CEO sets PHARMExcel apart from other CROs"
Biotech Sponsor
PHARMExcel is a UK-based CRO with more than 15 years of clinical research experience, trusted by academic and commercial sponsors for its high-quality study delivery and hands-on senior oversight. Our cross-functional teams bring together expertise in global clinical operations, regulatory strategy, medical oversight and data-driven trial management to support Phase I–IV research across a wide range of therapeutic areas.
As a full-service CRO, we combine scientific rigour with a collaborative, people-first approach. Our process ensures consistent communication, reduced oversight burden and reliable delivery from study start-up all the way through to monitoring and close out. Sponsors value our ability to act as an extension of their own team. We offer clear guidance, operational consistency and the agility needed to navigate clinical programmes that have many moving parts.
Rooted in quality standards and certified to ISO 9001 standard, PHARMExcel is committed to delivering clinical research with integrity, transparency and true patient focus.
We know that successful partnerships can only be advanced where there is a true understanding of requirements and expectations. PHARMExcel welcome the opportunity to learn more about your specific needs so we can best determine the right delivery approach for you.